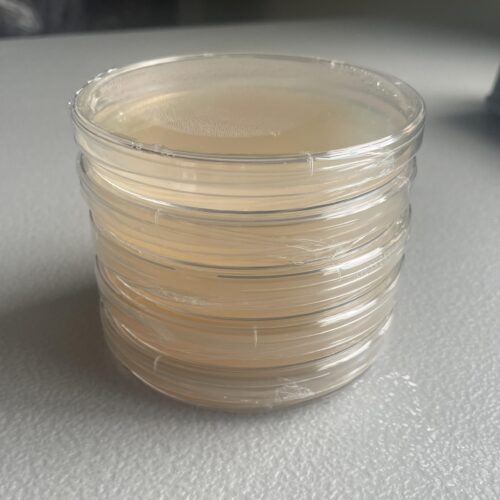

Description
LME Agar Plate 5 Pack
Disclaimers
AGAR PLATES MUST BE PURCHASED SEPARATELY FROM THE GENETICS OF ACTIVE MUSHROOMS. WE DO NOT CONDONE IN CULTIVATING ACTIVE MUSHROOM SPECIES.
WE ARE NOT RESPONSIBLE FOR TEMPERATURE RELATED DAMAGE. IF IT IS BELOW 32°F OR 100°F IN YOUR AREA OUR TEMPERATURE SENSITIVE SHIPPING OPTION IS HIGHLY RECOMMENDED.
WE ARE NOT RESPONSIBLE FOR ANY PLATE CONTAMINATIONS AFTER YOU OPEN THE SEAL. IF THE PLATE IS CONTAMINATED BEFORE YOU USE IT PLEASE EMAIL US.
Agar Plate Information
These are standard sized agar plates that we pour in house. All of our agar plates are poured and sealed in front of a HEPA flow hood to ensure cleanliness. They are uncolonized so you can put your desired mushroom genetics on them. These are LME (Light Malt Extract) plates that work incredibly well with most mushroom species.
THIS IS A LIMITED TIME DEAL
LME Agar Plate 5 Pack Contents
Where you order our 5 pack of agar plates you will receive:
- 5 uncolonized, sealed agar plates
- 2 alcohol prep pads
- 1 sticker

Reviews
There are no reviews yet.